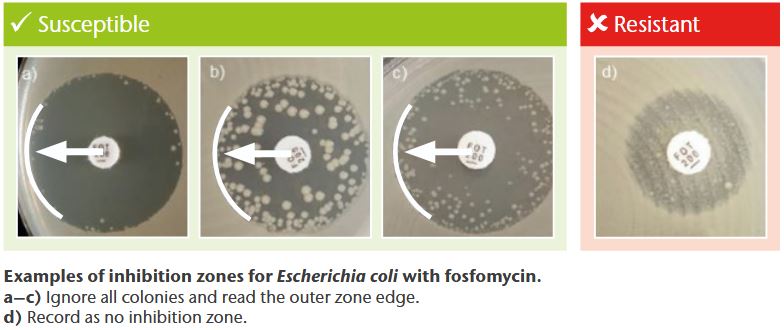
Inhibition Zones Inhibition Zones

EUCAST Guidance
AST methods for IV Fosfomycin

General notes
- Agar dilution is the reference method for IV fosfomycin recommended by EUCAST
- Minimum inhibitory concentrations (MICs) must be determined in the presence of glucose-6-phosphate (G6P) (25 mg/L in the medium)
- Recommended medium for agar dilution or other diffusion methods: Mueller-Hinton agar
- Isolated colonies within the inhibition zone can be ignored in disk diffusion testing (only E. coli)
- Follow manufacturer‘s instructions for commercial systems (available systems include gradient tests, automated systems, and ready-to-use agar dilution panels)
Monotherapy
EUCAST Breakpoint Tables 1

Examples of interesting inhibition zones for E. coli (agar diffusion testing)
Combination therapy
EUCAST Breakpoint Tables 1

Interpretation of EUCAST breakpoint tables
- For agents used primarily in combination with other antibiotics, EUCAST does not provide clinical breakpoints but introduced the concept of breakpoints in brackets 1
- Limited data show no evidence to suggest that the ECOFF (determined for fosfomycin alone) is predictive of clinical efficacy in combination therapy. Thus, no breakpoints in brackets have been established for IV fosfomycin 2,α
- However, these data suggest that treatment success of IV fosfomycin in combination is possible up to or even above species-specific ECOFFs, indicating that even isolates with high MICs can still be effectively treated in combination therapyγ
- The use of IV fosfomycin in combination therapy is therefore a primarily clinical decision #
- Nonetheless, (T)ECOFFs can be used to monitor acquired resistance (i.e., to distinguish between wild-type isolates and isolates with acquired resistance (non-wild type))β
Rationale for the clinical use of IV Fosfomycin in combination therapy
- Therapy-relevant, substance-specific properties including
– high plasma3-6 and tissue levels7-13 including attainment of PK/PD targets3, 4, 14-25
– excellent tissue penetration properties 26 (i.e., difficult-to-reach compartments/deep-seated infections)
– biofilm 27-29 and intracellular activity30,31
– synergy with many antibiotic classes32
– bactericidal activity, good tolerability with a broad antimicrobial spectrum33 - Available clinical data in the approved indications34-52
- Recommendations in guidelines/expert opinions 53-71 (e.g., for the treatment of infective endocarditis, complicated urinary tract infections, sepsis, nosocomial pneumonia, CNS infections, bone and joints infections, soft/skin tissue infections
EUCAST guidance on when there are no breakpoints
EUCAST provides a flowchart on how to proceed for species where clinical breakpoints are lacking. The guidance document can be accessed using this link: https://www.eucast.org/fileadmin/src/media/PDFs/EUCAST_files/Guidance_documents/Use_of_fosfomycin_iv_breakpoints_General_advice_20240528.pdf

